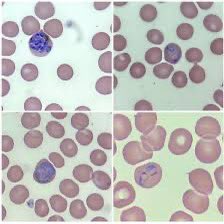
Rafa Toledo tweet media

Emma Carmelo retweetledi
Emma Carmelo
7.3K posts

Emma Carmelo
@emmacarpas
Parasitóloga, investigadora del Instituto de Enfermedades Tropicales de Canarias y profesora de la ULL. Mis tuits son mis opiniones.
Katılım Kasım 2011
419 Takip Edilen453 Takipçiler
Emma Carmelo retweetledi
Emma Carmelo retweetledi

👾 ¿Cómo uso Claude?
La inteligencia artificial dio un salto en diciembre. DE GOLPE. "Los agentes de código no funcionaban y desde entonces sí funcionan", dijo @karpathy.
Cuento qué ha pasado.
Y cómo podría ayudarte👇
Español
Emma Carmelo retweetledi
Emma Carmelo retweetledi

NUEVOS VIRUS que vendrán de Asia...
La IA y la genómica pueden predecir qué virus de garrapatas saltarán a los humanos. 🧵👇
1️⃣ Se han identificado 230 virus emergentes transmitidos por garrapatas (TBVs). ¡Solo estamos viendo la punta del iceberg! 🧊🔬
2️⃣ Investigadores han desarrollado un modelo genómico que analiza la polimerasa del virus (RdRp) para detectar el riesgo zoonótico. Identificaron 25 virus de "muy alto riesgo" que pueden causar brotes. 🤖🧬
3️⃣ Validación Clínica: El modelo ya validó 3 nuevos patógenos humanos que antes pasaban desapercibidos. Pasamos de una reacción "reactiva" a una prevención "proactiva". 🏥✅
4️⃣ Hotspots: La garrapata asiática Haemaphysalis longicornis y el ganado (ovejas 🐑) son los principales reservorios. Asia es el epicentro de estos hallazgos. 🌏🛰️
#SaludGlobal #Garrapatas #Virología #InteligenciaArtificial #Ciencia #OneHealth #Zoonosis #virus #epidemia #pandemia
🔗 👇 @SEMicrobiologia cell.com/trends/parasit…


Español
Emma Carmelo retweetledi

New tool to strengthen the fight against #malaria 🌍
The MARC SE-Africa Antimalarial Resistance Dashboard brings together the latest data to monitor and respond to emerging drug resistance across 19 endemic countries.
Supported by @EDCTP3
🔗 Explore it: samrc.ac.za/antimalarial-d…

English

Un paso histórico contra la Enfermedad del sueño: la Agencia Europea de Medicamento emite un informe favorable para la
primera terapia de dosis única desarrollada por @DNDi y Sanofi share.google/HVKCYet0LF9ukD…
Español
Emma Carmelo retweetledi

Hoy, #8M – Día Internacional de la Mujer, desde @Tecno_Mac reafirmamos nuestro compromiso con la igualdad entre mujeres y hombres, un principio clave para una cooperación más inclusiva y sostenible.💜
#DíaInternacionalDeLaMujer #Igualdad #TecnoMac #InterregMAC @INTERREGMAC

Español
Emma Carmelo retweetledi

🤝 El Consejo General de Farmacéuticos, de la mano de @farmamundi y @fundelalto, y con la colaboración de @cinfasalud, edita una guía de buenas prácticas que recoge todo lo que hay que saber sobre la cooperación farmacéutica.
📰 NP: farmaceuticos.com/noticias/el-co…
#DíaMundialdelasONG #FarmaciaSocial

Español
Emma Carmelo retweetledi

🔬Durante su estancia formativa, dentro del programa #Tecnomac, la investigadora Letizia Branco analizó muestras ambientales con técnicas de biología molecular para estudiar la diversidad microbiana.



Español
Emma Carmelo retweetledi

Diálogos para comprender la LMC
Herramientas para preparar la consulta y comunicar síntomas, preocupaciones y necesidades + sesión de dudas con profesionales.
📍 La Laguna Gran Hotel | 🗓️ Jueves 5 de marzo de 2026 | 🕔 17:00–19:00
#LMC #Salud #Hematología #Tenerife
@Aelemic

Español
Emma Carmelo retweetledi

👩🔬 Centenares de docentes e investigadoras de la #ULL han participado en el proyecto educativo Chicas con @CienciaULL desde su comienzo en 2020.
Hoy, Día Internacional de la Mujer y la Niña en la Ciencia, es un momento ideal para ver algunos de sus vídeos o incluso deleitarse con los libros publicados.
Vídeos por temporadas 🎥ull.es/portal/ciencia…
Libros 📙 ull.es/portal/ciencia…

Español
Emma Carmelo retweetledi

👩🔬Con motivo del Día Internacional de la Mujer y la Niña en la Ciencia, les invitamos a consultar el libro de la serie del proyecto educativo Chicas con Cienci@ULL
Libro completo👉 ull.es/portal/ciencia…
Por temporadas 👉 ull.es/portal/ciencia…
#TodasconCienciaULL

Español
Emma Carmelo retweetledi

𝗧𝗲𝗰𝗻𝗼𝗠𝗮𝗰 es un un proyecto de investigación financiado por el programa europeo Interreg MAC. Si deseas profundizar en este proyecto, visita su página web: tecnomac.site
@ULL #TecnoMAC #InterregMAC #SeguridadAlimentaria
Español
Emma Carmelo retweetledi

Uno de los principales objetivos del proyecto @Tecno_Mac, en el que participa el #IPNA, es detectar y cuantificar pesticidas en productos hortofrutícolas destinados al consumo humano, para comprobar si cumplen con los límites legales y son seguros para la población



Español
Emma Carmelo retweetledi

🔶Hoy, te explicamos los últimos acontecimientos que se están produciendo en España alrededor del #sarampión (y por qué es importante que los adultos también se vacunen contra la #infección)
📈 Esta #enfermedad aumentó su incidencia de forma sustancial en 2025 respecto a años anteriores, con casi 400 casos registrados
Más información 👇

Español
Emma Carmelo retweetledi

📚 Ya puedes consultar el "Documento de posicionamiento de @GepiSeimc sobre la vacunación frente a #Chikungunya en viajeros"
➡️ En las últimas décadas, esta #infección ha experimentado una notable expansión geográfica, con brotes recurrentes en Asia, Centro y Sudamérica, y episodios de #transmisión autóctona en Europa
Léelo aquí 👇
seimc.org/wp-content/upl…

Español
Emma Carmelo retweetledi

🟣 Farmacias comunitarias: aliadas frente a la violencia contra las mujeres. Protocolo actualizado para detectar, acompañar y derivar con seguridad.
@Farmaceuticos_
n9.cl/4iu4c8
#FarmaciaComunitaria #CruzVioleta #ViolenciaContraLasMujeres

Español
Emma Carmelo retweetledi

‼️Primera detección de anticuerpos frente a #GripeAviar #H5N1 en una vaca en Europa.
Era cuestión de tiempo (y buenos estudios de campo)...
Va hilo⬇️

Español
Emma Carmelo retweetledi

Cerramos 2025 con una nueva edición de nuestro #DiarioCanarina, una publicación trimestral donde mostramos los disparates que han ocupado las páginas de prensa en #Canarias.

Español